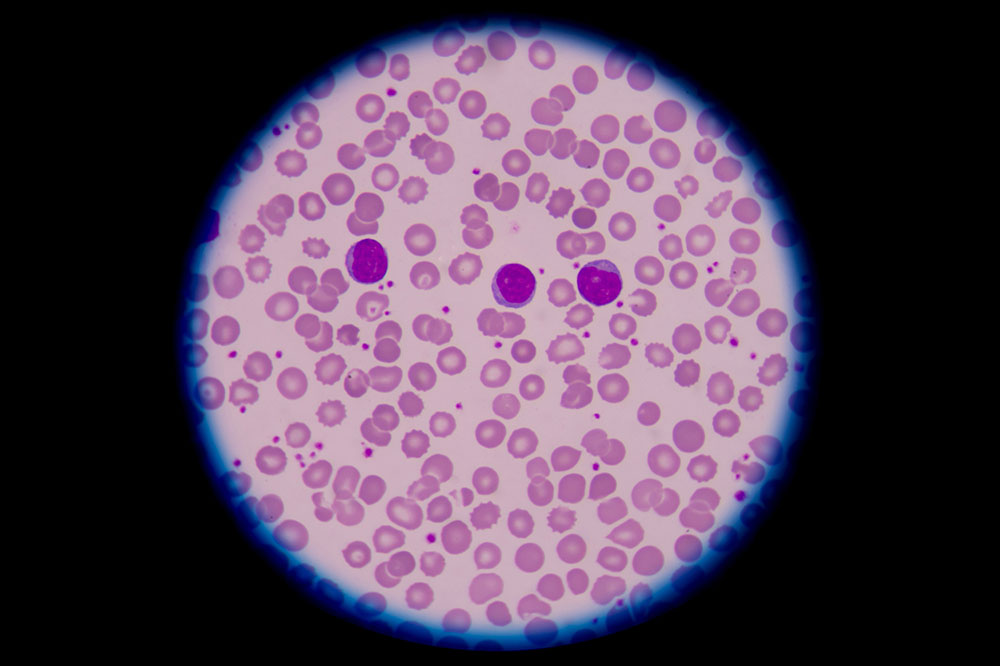
Everything you need to know about blood disorders

Everything you need to know about blood disorders
Blood disorders are conditions that cause problems in your blood or bone marrow. Bone marrow is a spongy tissue inside your bones that is responsible for the production of white blood cells, red blood cells, and platelets. When anything goes wrong with either of these cells or with clotting factors in the plasma, an individual is diagnosed with a blood disease or disorder. Having said this, let’s take a look at symptoms of these disorders, their various types, and how they are treated.
Symptoms
Blood disorders generally reduce the number of cells, platelets, or nutrients in the blood, or interfere with the normal functioning.
- Disorders that affect red blood cells in your body cause fatigue, shortness of breath, muscle weakness, headache, or dizziness because of the lack of oxygenated blood in the brain, or rapid heartbeat.
- Disorders that affect white blood cells in your body often gives rise to chronic infections, and unexplained weight loss, and exhaustion. If people with this disorder are injured, their wounds take an unusually long time to heal.
- Platelets and clotting disorders cause difficulties in forming blood clots at wound sites or controlling bleeding, lead to injuries that are slow to heal or keep re-opening, cause sensitive skin that bruises easily, and also unexplained nosebleeds or bleeding from the gums.
Types and causes
Blood disorders are mostly inherited from parents. But sometimes, they can be acquired because of toxic exposure, infection, drug side effects, or lack of nutrients like iron, vitamin K, or vitamin B12, in your diet. The various types of blood cell disorders are:
- Red blood cell disorders : These cells transfer blood from the lungs to all parts of your body. Any disorder that affects these cells interferes in the process of the blood flow. Some common red blood cell disorders include anemia, thalassemia, and polycythemia vera.
- White blood cell disorders : These blood cells help guard your body against infection and foreign substances. Any disorder in white blood cells directly impacts your body’s immune system. Lymphoma, leukemia, and myelodysplastic syndrome (MDS) are some common white blood cell disorders.
- Platelet disorders: Platelets help control bleeding. An individual with this disorder might have too many platelets, or very few platelets, or platelets that don’t clot properly. Some common platelet disorders include hemophilia and von Willebrand disease.
- Plasma cell disorders: Plasma cells carry components that help stop bleeding and prevent blood clot formation. Plasma cell myeloma is a type of blood cancer that results in the accumulation of plasma cells in the bone marrow.
Treatment
Treatment for blood disorders is determined by the cause of your illness, age, and overall health. The doctor may use multiple treatments to help correct blood cell disorder. Some chronic disorders have no specific treatment but may require it if the condition worsens. Some common blood disorders, such as anemia, caused by lack of iron, is treated with iron supplementation. Whereas, hemophilia can be treated with something called as replacement therapy, which involves the injection of a clotting factor or plasma.